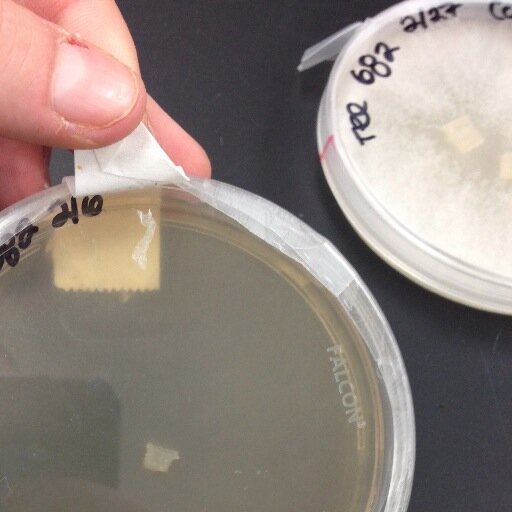
petmicrobe's profile picture. Yo, my name is Gus. I like to have fun, because I'm a #Fungi #FunGusLyfe #AGARlyfe

#streakingmethod search results
Helping undergraduates understand Basic Microbiological Techniques via rountine practicals feels good...#microbiology #basictechniques #streakingmethod #generalmicrobiology #bacteriaisolation #bacteriaidentification #rountinepraticals #unizik #nau #graduateassistant

P.S. streaking in the agar just made u dig yourself deeper into the friend zone. I got #mycotoxinSWEG?! #selectionpressure #streakingmethod
Helping undergraduates understand Basic Microbiological Techniques via rountine practicals feels good...#microbiology #basictechniques #streakingmethod #generalmicrobiology #bacteriaisolation #bacteriaidentification #rountinepraticals #unizik #nau #graduateassistant

P.S. streaking in the agar just made u dig yourself deeper into the friend zone. I got #mycotoxinSWEG?! #selectionpressure #streakingmethod
Helping undergraduates understand Basic Microbiological Techniques via rountine practicals feels good...#microbiology #basictechniques #streakingmethod #generalmicrobiology #bacteriaisolation #bacteriaidentification #rountinepraticals #unizik #nau #graduateassistant

Something went wrong.
Something went wrong.
United States Trends
- 1. Steelers 52.9K posts
- 2. Rodgers 21.3K posts
- 3. Chargers 38K posts
- 4. Tomlin 8,366 posts
- 5. Resign 109K posts
- 6. Schumer 229K posts
- 7. Mr. 4 4,844 posts
- 8. Tim Kaine 20.8K posts
- 9. Sonix 1,195 posts
- 10. #BoltUp 3,066 posts
- 11. Dick Durbin 13.5K posts
- 12. 8 Democrats 9,672 posts
- 13. Rudy Giuliani 10.5K posts
- 14. Angus King 17.4K posts
- 15. #ITWelcomeToDerry 4,878 posts
- 16. Keenan Allen 5,062 posts
- 17. 8 Dems 7,545 posts
- 18. #RHOP 7,081 posts
- 19. #HereWeGo 5,736 posts
- 20. Maggie Hassan 17.7K posts